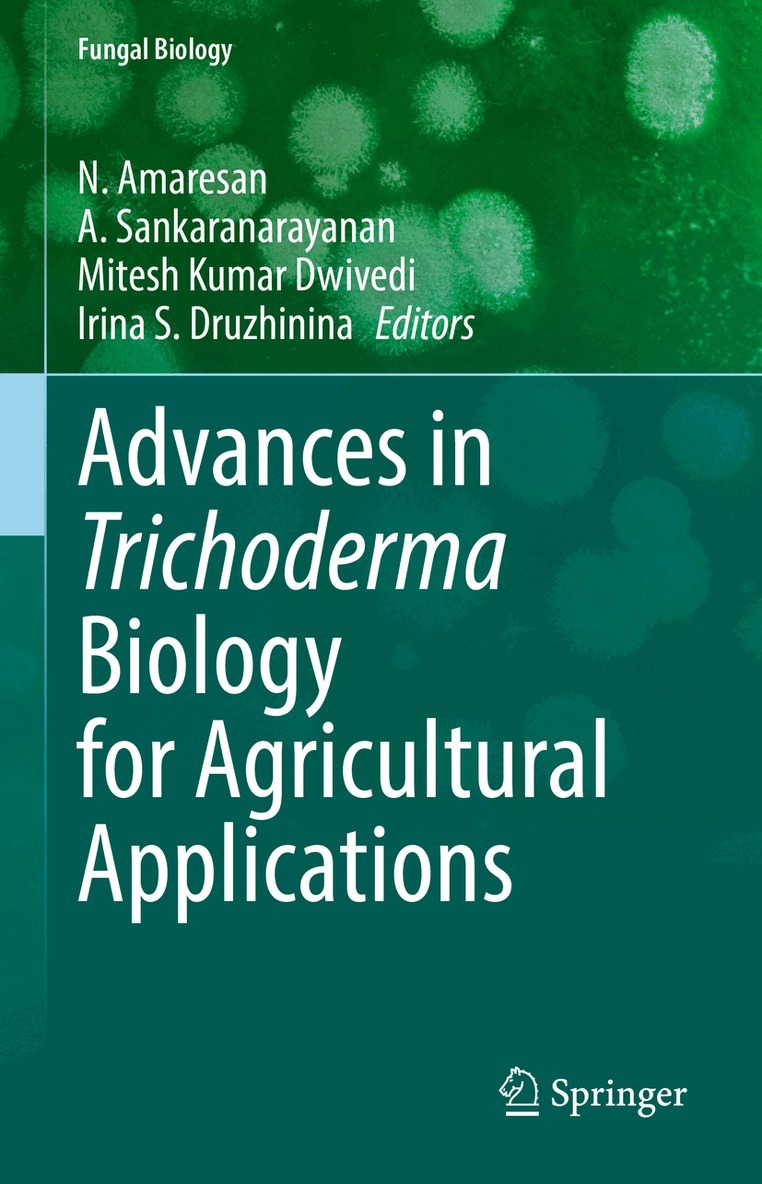

Beneficial Microbes in Agro-Ecology
N. Amaresan, M. Senthil Kumar, K. Annapurna, Krishna Kumar, A. Sankaranarayanan
Häftad, 2020
3 770 kr
Du är på sajten för privatpersoner.
AvN. Amaresan,Senthilkumar Murugesan
2 369 kr
Beställningsvara. Skickas inom 10-15 vardagar. Fri frakt över 249 kr.
Dr. N. Amaresan is an Assistant Professor at C.G. Bhakta Institute of Biotechnology, Uka Tarsadia University, Gujarat. He is basically a Microbiologist, obtained Ph.D., degree on endophytic PGP bacteria from Bharathidasan University, Tamil Nadu. Dr. N. Amaresan has over thirteen years of experience in teaching & research and made several original and novel discoveries, especially in various allied fields of microbiology mainly plant-microbe interactions, bioremediation, plant pathology and others. For his original discoveries on agriculturally important microorganisms he has been awarded young scientist awards by Association of Microbiologists of India and National Academy of Biological Sciences. He has also been awarded visiting scientist fellowship from National Academy of India to learn advanced techniques. He has handled two institute funded and four externally funded projects from DST, GEMI, DBT etc. He has published more than 50 research articles and books of national and international reputes. He also deposited over 350 bacterial 16S rDNA and fungal ITS rDNA sequences in the Genbank (NCBI, EMBL & DDBJ) and also preserved over 150 microbial germplasm in various culture collection centres of India.Dr. Senthilkumar Murugesan is currently working as Principal Scientist (Microbiology) at ICAR-Indian Institute of Pulses Research, Kanpur. He obtained Ph.D (Microbiology) from Indian Agricultural Research Institute, New Delhi and received post-doctoral fellow from Korean Atomic Energy Research Institute, South Korea. He had twenty years of research experience on different aspects of plant-microbe interactions including symbiotic nitrogen fixation, biological control and microbial mediated abiotic stress management in pulses. He explored the diversity of endophytic bacteria from wild and cultivated soybean varieties for biological control of soybean charcoal rot disease. He purified anti-microbial peptides from soybean endophytic bacteria. He has developed bioinoculants and microbial consortia for improving moisture-deficit stress tolerance of rainfed chickpea. He has published more than 20 research papers in peer reviewed journals. He is the Fellow of Indian Society of Pulses Research and Development (ISPRD).Dr. Krishna Kumar presently working as a Dean, Pandit Deendayal Upadhyay College of Horticulture & Forestry Dr. Rajendra Prasad Central Agricultural University, Muzaffarpur, Bihar, India. He worked as a Research Associate at IARI, New Delhi, Assistant Professor at SKUAST, Jammu and then served as a Senior Scientist and Principal Scientist at Central Agricultural Research Institute, Port Blair. He served as a Principal Scientist at Indian Agricultural Research Institute, New Delhi, India. He has also worked as a Head, Division of Crop Protection in Indian Institute of Pulses Research, Kanpur, India. He has over 20 years of research, teaching and extension experience in mushroom production, bio-control, microbial diversity, integrated disease management, diagnosis of unknown plant diseases and suitable bio-control agents. He is a recipient of Fakhruddin Ali Ahmed Award for Outstanding Research in Tribal Farming Systems-2010 by Indian Council of Agricultural Research, New Delhi, India, SPPS Meritorious Scientist Award-2011 by Society of Plant Protection Sciences, New Delhi, India and Distinguished Service Award-2010 for his contribution in Plant Pathology by BIOVED Research Society, Allahabad, Uttar Pradesh, India. He is a fellow of three prestigious professional societies and life member of 12 scientific societies. He also deposited 42 microorganisms at National Bureau of Agriculturally Important Microorganisms (NCBI) and submitted 400 sequences of them to NCBI. He delivered several radio talks and TV shows on different topics for the benefit of farming community. Dr. Sankaranarayanan is associated with C.G. Bhakta Institute of Biotechnology, Uka Tarsadia University, Surat of Gujarat state of India from 2015 onwards. He has experience in the fields of Antimicrobial activity of herbal and nano particles against MDR pathogens and fermented food products. His current research focus is on microbes in fermented food products, removal of bacteria from food by Dielectrophoresis. He has published 15 chapters in books, 50 research articles in International and National journals of repute and he authored 5 books which published by International publishers, guided 5 Ph.Ds and 16 M.Phil., scholars and operated 5 external funded minor projects and two Institute funded projects. From 2002 -2015, he worked as an Assistant Professor & Head, Department of Microbiology, K.S.R. College of Arts & Science, Tiruchengode, Tamil Nadu. He has awarded with Indian Academy of Sciences (IASc), National Academy of Sciences (NAS) and The National Academy of Sciences (TNAS) sponsored summer research fellowship for young teachers consecutively for three years. His name is included as a Mentor in DST-Mentors/Resource persons for summer/winter camps and other INSPIRE initiatives, Department of Science & Technology, Govt. of India, New Delhi. He is a Grant reviewer in British Society of Antimicrobial Chemotherapy (BSAC), UK. He has involved himself in the organization of various National / International seminars / Symposia. He is actively involved as an Editor / Editorial board members in journals and reviewers in various International / National reputed journals and acted as an external examiners to adjudicate the Ph.D., thesis of various Universities in India.

N. Amaresan, M. Senthil Kumar, K. Annapurna, Krishna Kumar, A. Sankaranarayanan
Häftad, 2020
3 770 kr

D. Dhanasekaran, Dhiraj Paul, N. Amaresan, A. Sankaranarayanan, Yogesh S. Shouche
Inbunden, 2021
2 869 kr
N. Amaresan, A. Sankaranarayanan, Mitesh Kumar Dwivedi, Irina S. Druzhinina
Inbunden, 2022
1 835 kr


N. Amaresan, A. Sankaranarayanan, Mitesh Kumar Dwivedi, Irina S. Druzhinina
Häftad, 2023
1 835 kr

A. Sankaranarayanan, Natarajan Amaresan, Mitesh Kumar Dwivedi
Häftad, 2023
1 405 kr

Mitesh Kumar Dwivedi, Natarajan Amaresan, A. Sankaranarayanan, Rasheedunnisa Begum
Häftad, 2022
1 674 kr

Mitesh Kumar Dwivedi, A. Sankaranarayanan, E. Helen Kemp, Yehuda Shoenfeld
Inbunden, 2023
2 210 kr

Mitesh Kumar Dwivedi, A. Sankaranarayanan, E. Helen Kemp, Yehuda Shoenfeld
Häftad, 2024
2 210 kr

D. Prasad, C. S. Rajan, A. Sankaranarayanan, J. Sengupta
Inbunden, 2013
1 615 kr